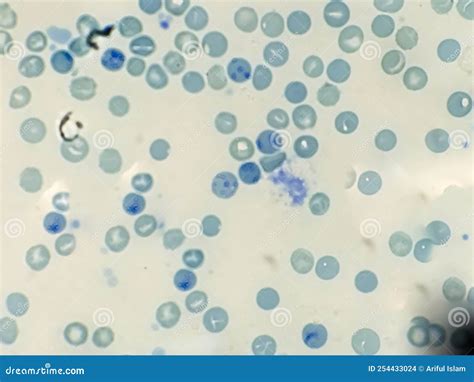

Capire se il lievito di birra è ancora buono è fondamentale per garantire il successo delle tue ricette. Vediamo insieme cosa succede quando il lievito è scaduto e come verificarne l'efficacia.
Cos'è il Lievito di Birra?
Il lievito di birra è un fungo microscopico, formato da colonie di Saccharomyces cerevisiae, ottenute per fermentazione. Le cellule del lievito vengono coltivate su un substrato di malto (orzo germogliato) all’interno di fermentatori dove si moltiplicano migliaia di volte. Alla fine di tale processo, le cellule vengono separate dal substrato nutritizio, lavate ed essiccate ad una temperatura che non supera i 40 gradi centigradi.
Cosa Contiene il Lievito di Birra?
Il lievito di birra costituisce una fonte ricca e completa di vitamine B, spesso assunte in scarse quantità nelle diete iperlipidiche, o iperglucidiche, o iperproteiche, oppure quando il consumo di alcool, sigarette o caffè è elevato. Il gruppo B è un insieme di vitamine molto importante anche per gli sportivi, i bambini in crescita e le persone convalescenti, perché facilita la trasformazione di proteine, carboidrati e lipidi in energia.
Il lievito di birra contiene tutte le vitamine del gruppo B, dosate in buone proporzioni per una loro corretta integrazione (le vitamine del complesso B agiscono in sinergia fra loro, intervenendo sui sistemi di regolazione del metabolismo). Fa però eccezione la vitamina B12, carente nelle diete vegane, essendo tipica del regno animale. Nel lievito di birra, alle vitamine del gruppo B si aggiungono selenio, cromo (cofattore dell’insulina e preventivo del diabete mellito), glutatione, zolfo, aminoacidi essenziali (leucina, valina, isoleucina, treonina, fenilalanina, metionina, triptofano, lisina) fosforo, potassio e magnesio.
Fonte: mypersonaltrainer.it
Differenza tra Lievito e Lievito di Birra
La differenza principale con il lievito di birra è la presenza di una grande quantità di batteri lattici che, naturalmente contenuti nella farina, trovano modo e tempo di svilupparsi.
Come Verificare se il Lievito di Birra Scaduto è Ancora Utilizzabile
Per capire se il proprio lievito di birra, passata la data di scadenza scritta sulla confezione, è andato davvero a male e quindi non è più utilizzabile bisogna innanzitutto verificare il colore di questo prodotto. Quindi, la prima cosa da fare è aprire la confezione e controllare di che colore è il proprio lievito. Se è beige è ancora buono mentre se il colore inizia a diventare grigiolino o se si vedono macchie di muffa allora il lievito non sarà più utilizzabile in cucina.
Non è detto, però, che un lievito andato a male presenti questi cambi di colore sulla superficie, quindi, per controllare la sua effettiva efficacia basterà scioglierlo in un bicchiere di acqua tiepida insieme a un po’ di zucchero (è importante usare l’acqua tiebida e non bollente perché altrimenti si annullerà l’effetto lievitante del fungo). Se dopo un po’ di tempo si formeranno delle bolle, il lievito di birra è ancora attivo e quindi potrà essere ancora utilizzato per preparare le vostre ricette preferite.

Tecniche e Impasti: L'Arte della Lievitazione
Altrettanto fondamentale della conoscenza delle materie prime è la padronanza delle lavorazioni. La lievitazione, l’impastamento, la sfogliatura influenzano decisamente il risultato finale.
Sul dizionario, alla voce “lievito”, si legge: «Insieme di funghi unicellulari, detti saccaromiceti, capaci di trasformare per via enzimatica gli zuccheri in alcol etilico e anidride carbonica; sono responsabili della lievitazione del pane e della fermentazione del vino e della birra; commercialmente sono usati come fonte di proteine e vitamine e nella sperimentazione di laboratorio, soprattutto nel campo dell’ingegneria genetica».
La leggenda attribuisce la scoperta del pane lievitato a una schiava egizia, che dimenticò la pasta destinata alla preparazione di alcune gallette. Su questa pasta si erano posati spontaneamente dei lieviti e l’avevano fatta gonfiare: la donna, non avendo tempo per prepararne altra, la fece cuocere così com’era. Il suo padrone gradi molto questo nuovo tipo di pane. In effetti, è proprio in Egitto che è nata l’arte della panificazione e della pasticceria. Nelle tombe egizie sono stati ritrovati semi di cereali e le ricette necessarie per prepararli.
LIEVITO MADRE PASTA MADRE come fare il lievito naturale lievito madre pasta madre in pochi giorni
La Storia del Lievito
La vera storia del lievito ci riporta al 1680 quando, utilizzando un microscopio, il ricercatore Antoni van Leeuwenhoeck osservò i globuli del lievito di birra per la prima volta. Solo nel 1857, però, grazie al lavoro dello scienziato francese Louis Pasteur, il processo di fermentazione fu finalmente compreso: Pasteur riuscì a stabilire il ruolo chiave del lievito come responsabile della fermentazione alcolica. Lo scienziato aveva ben presto compreso che il lievito è indispensabile per ottenere gli aromi e i sapori del pane. Nel corso della storia, il lievito per panificazione, Saccharomyces cerevisiae, si è imposto in tutto il mondo come il migliore per far crescere gli impasti.
Tipi di Lievitazione
- Lievitazione fisica: Utilizzata soprattutto in pasticceria per prodotti come meringhe e pan di Spagna.
- Lievitazione chimica: Utilizzo di agenti lievitanti chimici come bicarbonato di ammonio e bicarbonato di sodio.
- Lievitazione biologica: La più utilizzata in panificazione, con l'uso di Saccharomyces cerevisiae (lievito di birra) o lievito madre.
Il Lievito Compresso
Il lievito compresso è costituito per due terzi da acqua e per un terzo (sostanza secca) da proteine, carboidrati (fra cui trealosio, lo zucchero disaccaride costituente della parete cellulare), una piccola quantità di fibra (circa il 6%), pochi lipidi e sali minerali. La composizione del lievito compresso varia in base al suo utilizzo. I ceppi contenenti più proteine sono più rapidi nell’azione, hanno una velocità di fermentazione più alta, ma non sono consigliati per gli impasti contenenti molto zucchero oppure per le produzioni che richiedono la surgelazione.
Il lievito compresso si conserva in frigorifero, alla temperatura di 1-4 °C. L‘ambiente di conservazione deve essere fresco e arieggiato, le confezioni del lievito devono essere chiuse in uno strato di carta e avvolte in pellicola per alimenti, in modo che il prodotto mantenga costante la propria umidità.
L’Attività Enzimatica del Lievito Compresso
Con «attività enzimatica” si intende l’attività degli enzimi zimasi, ossia la loro capacità di trasformare lo zucchero in anidride carbonica e alcol etilico. Per determinare l’attività enzimatica del lievito esistono diversi metodi.
- Metodo rapido: Si prepara una miscela composta da 6,5 g del lievito in esame, 7 g di farina e acqua in quantità tale da raggiungere la consistenza normale di un impasto. Il composto così ottenuto viene formato come un palloncino e messo in un bicchiere con acqua tiepida. Si calcola il tempo che passa dal momento in cui il palloncino è stato introdotto nel bicchiere fino al momento in cui sale in superficie. Questo tempo, per un lievito di buona qualità, deve essere intorno ai 20 minuti.
- Viene misurato lo sviluppo della pasta e, attraverso un sensore di pressione, l’aumento di pressione della pasta in fase di fermentazione.
Fonte: Piergiorgio Giorilli “La lievitazione lenta”
Lievito di Birra Scaduto: Si Può Usare?
Può succedere che avendo fatto scorta di lievito, con l’idea di congelarlo, ora vi trovate mezzo chilo di lievito di birra scaduto, in fondo al frigorifero. Se fresco, il lievito di birra non ha mai tempi di conservazione lunghissimi e capita spesso di acquistarlo e poi dimenticarselo.
Ricordatevi comunque che è un alimento naturale e “vivo”: fate attenzione e non sfidate eccessivamente la sorte, valutate le sue condizioni solo se la scadenza è superata da 2-3 giorni al massimo e non oltre.
Caratteristiche per Valutare il Lievito
- Colore: Il panetto di lievito di birra fresco si presenta color marroncino chiaro, omogeneo e senza macchie né aloni. Se notate angoli ossidati color grigio o marrone scuro, non usatelo. Ovviamente, non usatelo nemmeno se verificate la presenza di muffa o macchioline verdi, anche se piccole e superficiali.
- Superficie: Toccandolo, un lievito di birra fresco e sano risulta asciutto e non lascia traccia sulle dita. Se scaduto, può accadere che diventi unto e viscoso in superficie (controllate bene ogni lato): in questo caso va buttato.
- Consistenza: Se provate a spezzare un panetto di lievito, questo si romperà in maniera netta e tenderà a sbriciolarsi un po’. Se vi risulta invece elastico e colloso, e fatica a spezzarsi, non è più un lievito da usare.
- Odore: Tendenzialmente, dovrebbe avere un odore quasi neutro oppure vagamente di “formaggio”. Non deve essere un sentore pungente o fastidioso, non si deve sentire a distanza. In caso contrario tuttavia, non è detto che il lievito sia da buttare.
Verifica se il Lievito è Ancora Attivo
Se il vostro lievito di birra scaduto non dovesse presentare nessuna delle caratteristiche d’allarme elencate, non date per scontato che possa essere usato. Se sembra sano e intatto, potrebbe comunque essere inattivo, “morto”. attendete un’oretta senza mai toccare la miscela né mescolare. Un lievito ancora vivo e attivo, dopo un certo lasso ...